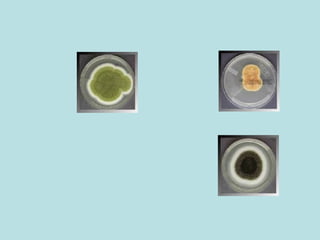

The document discusses several fungal infections including aspergillosis and systemic mycoses. It describes how aspergillus is an opportunistic infection that can cause invasive pulmonary disease in severely immunocompromised patients. A variety of laboratory tests can help diagnose aspergillosis including microscopy, culture, galactomannan assay and PCR. True systemic endemic mycoses like coccidioidomycosis, histoplasmosis, blastomycosis and paracoccidioidomycosis are also described with details on their causative agents, geographic distribution and methods for laboratory diagnosis.